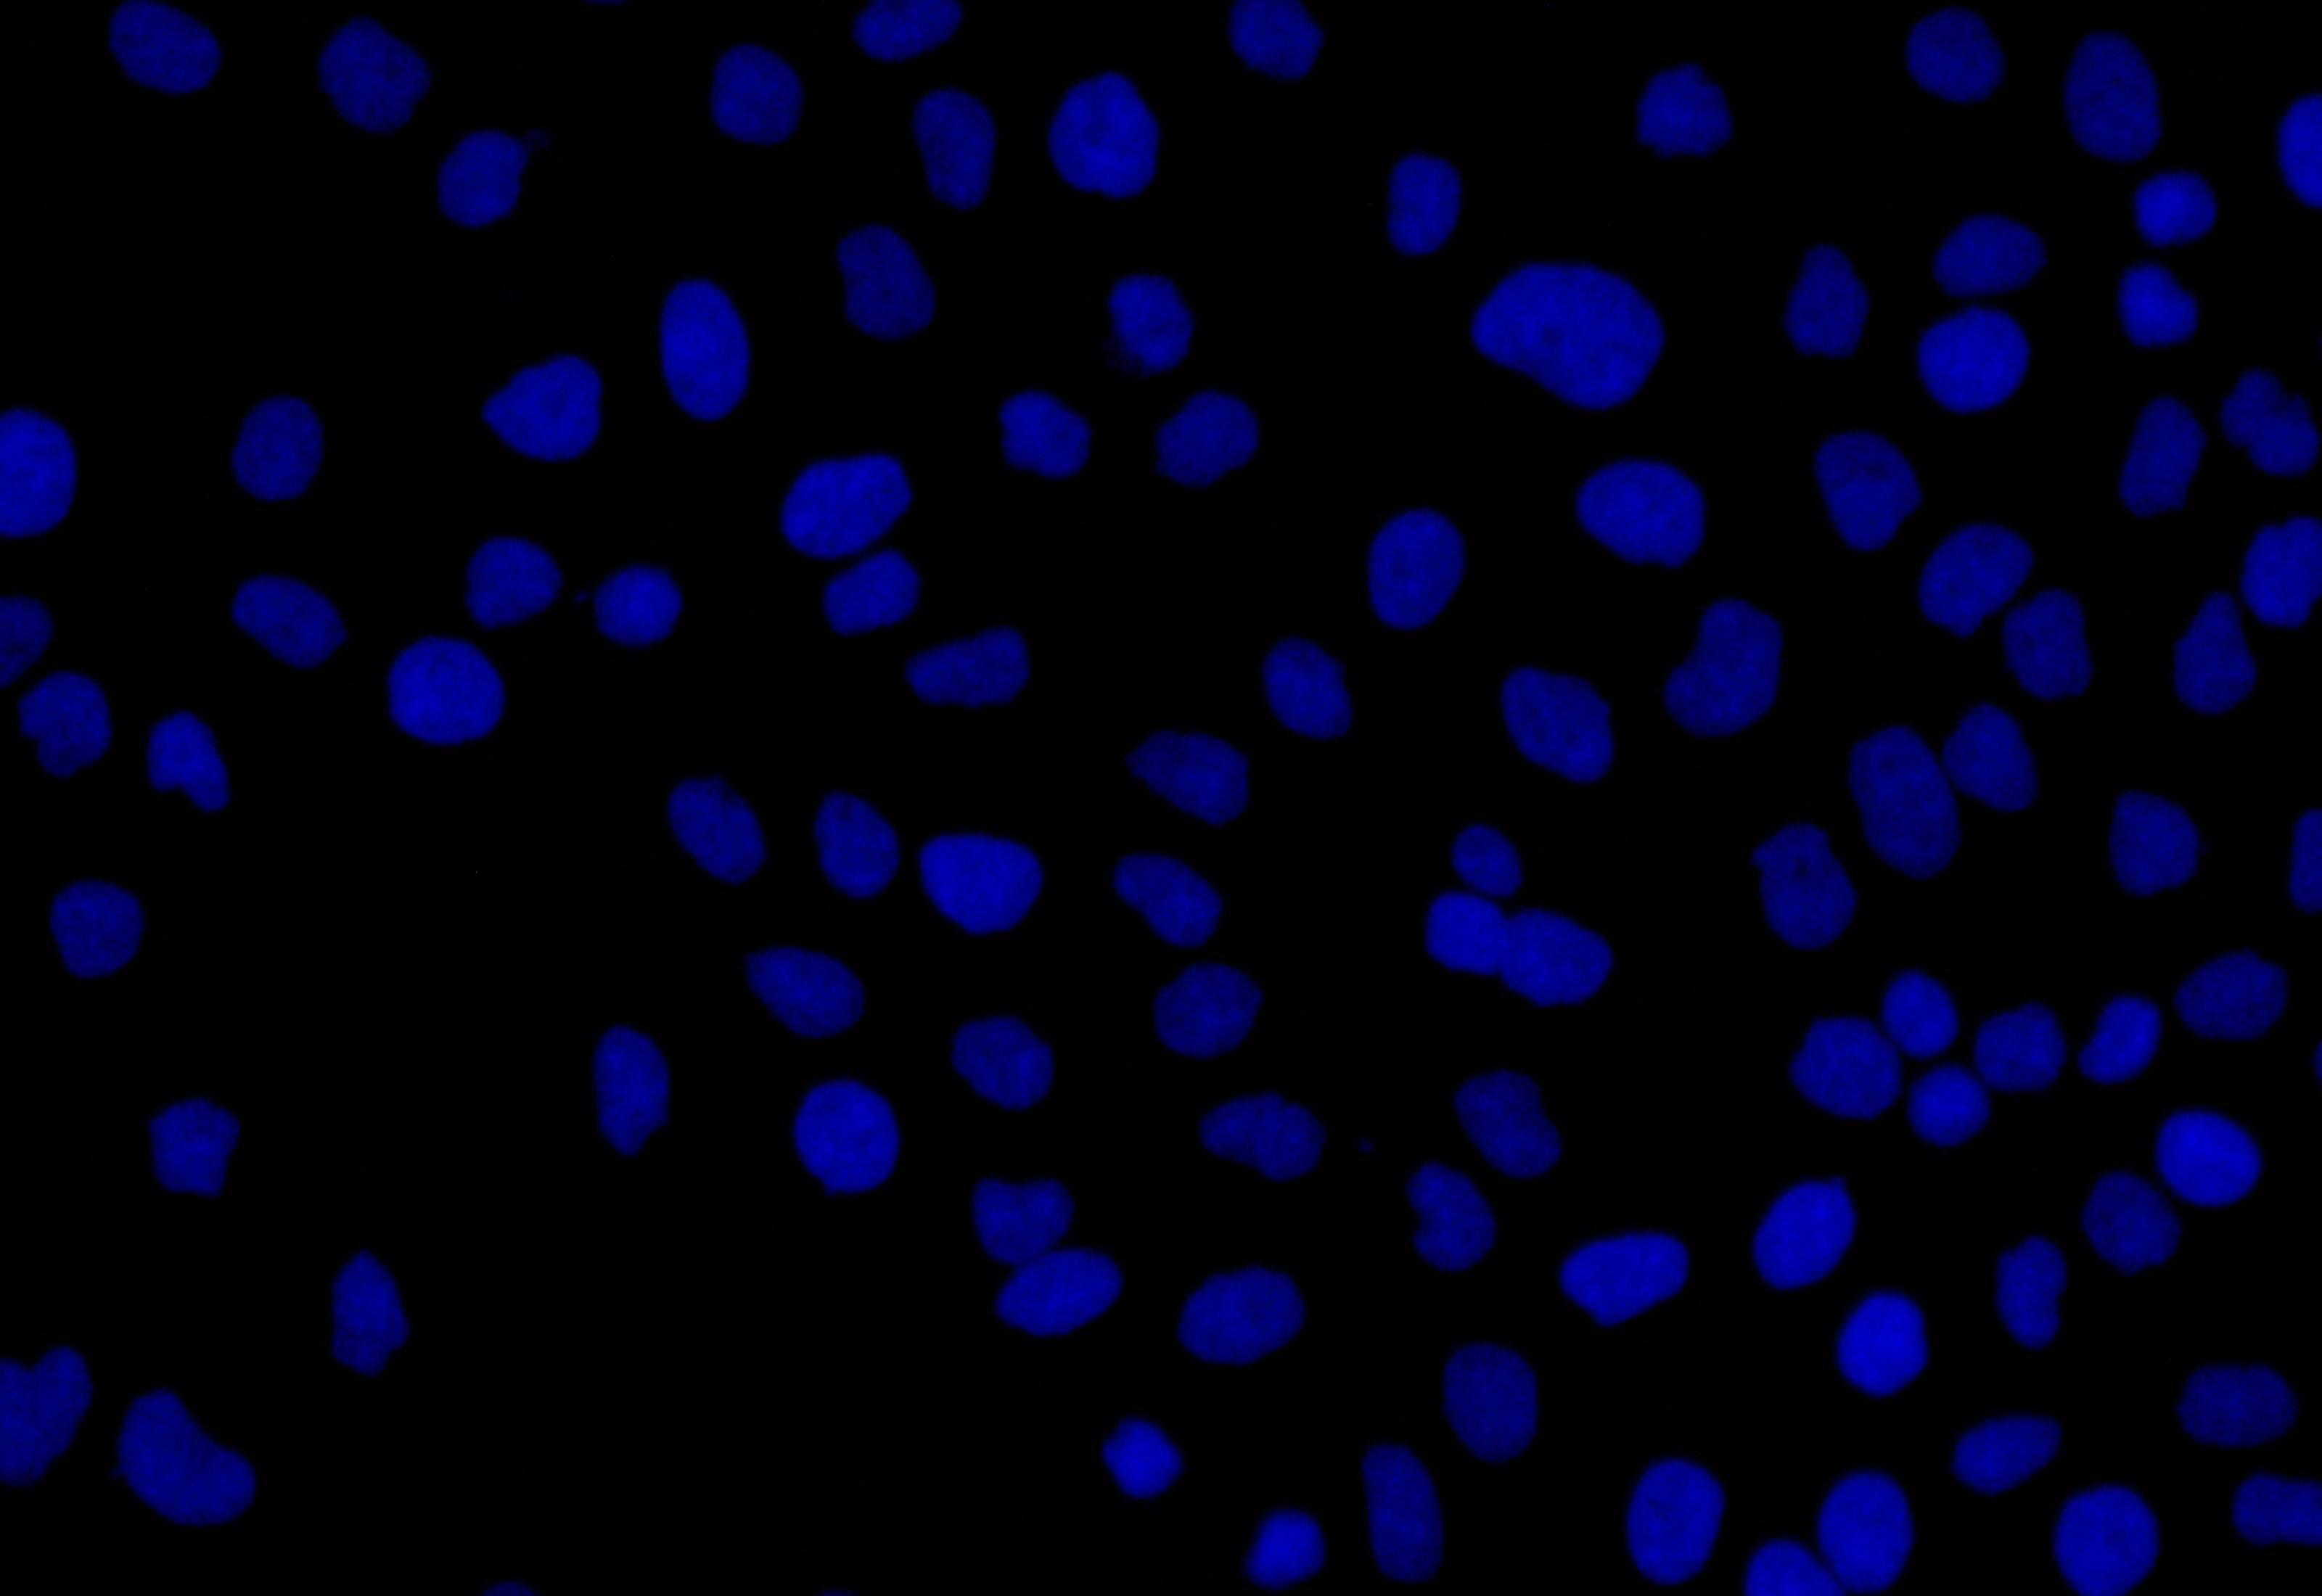

KLRK1 Antibody
-
中文名稱:KLRK1兔多克隆抗體
-
貨號:CSB-PA012474LA01HU
-
規格:¥880
-
圖片:
-
IHC image of CSB-PA012474LA01HU diluted at 1:50 and staining in paraffin-embedded human tonsil tissue performed on a Leica BondTM system. After dewaxing and hydration, antigen retrieval was mediated by high pressure in a citrate buffer (pH 6.0). Section was blocked with 10% normal goat serum 30min at RT. Then primary antibody (1% BSA) was incubated at 4°C overnight. The primary is detected by a Goat anti-rabbit polymer IgG labeled by HRP and visualized using 0.05% DAB. Secondary antibody only control: uses 1% BSA instead of primary antibody
-
Western Blot
Positive WB detected in: THP-1 whole cell lysate(30μg), A549 whole cell lysate(30μg), U251 whole cell lysate(30μg), Hela whole cell lysate(30μg)
All lanes: KLRK1 antibody at 1:1000
Secondary
Goat polyclonal to rabbit IgG at 1/20000 dilution
Predicted band size: 26kDa
Observed band size: 36 kDa
Exposure time: 120s -
Immunofluorescence staining of Hela cell with CSB-PA012474LA01HU at 1:20, counter-stained with DAPI. The cells were fixed in 4% formaldehyde and blocked in 10% normal Goat Serum. The cells were then incubated with the antibody overnight at 4C. The secondary antibody was Alexa Fluor 488-congugated AffiniPure Goat Anti-Rabbit IgG(H+L).
-
Immunofluorescence staining of Hela cell with 5% goat serum, counter-stained with DAPI. The cells were fixed in 4% formaldehyde and blocked in 10% normal Goat Serum. The cells were then incubated with the antibody overnight at 4C. The secondary antibody was Alexa Fluor 488-congugated AffiniPure Goat Anti-Rabbit IgG(H+L).
-
Immunofluorescence staining of A549 cell with CSB-PA012474LA01HU at 1:20, counter-stained with DAPI. The cells were fixed in 4% formaldehyde and blocked in 10% normal Goat Serum. The cells were then incubated with the antibody overnight at 4C. The secondary antibody was Alexa Fluor 488-congugated AffiniPure Goat Anti-Rabbit IgG(H+L).
-
Immunofluorescence staining of A549 cell with 5% goat serum, counter-stained with DAPI. The cells were fixed in 4% formaldehyde and blocked in 10% normal Goat Serum. The cells were then incubated with the antibody overnight at 4C. The secondary antibody was Alexa Fluor 488-congugated AffiniPure Goat Anti-Rabbit IgG(H+L).
-
-
其他:
產品詳情
-
產品描述:
The KLRK1 polyclonal antibody is a type of antibody that recognizes and binds to the human KLRK1 protein. The KLRK1 protein, also known as NKG2D, mainly functions to recognize and binds to stress-induced ligands expressed on the surface of infected or transformed cells, which allows the immune system to detect and eliminate these cells. KLRK1-mediated cytotoxicity is important for the immune response against viral infections and cancer, as well as for the elimination of cells undergoing cellular stress, such as cells undergoing DNA damage or apoptosis.
KLRK1 antibody is derived from multiple clones of B cells within the rabbit immunized with the recombinant human NKG2D protein (73-216aa), which produces a mixture of antibodies that can recognize different epitopes of the KLRK1 protein. The KLRK1 antibody underwent protein G affinity chromatography, getting a purity exceeding 95%. It has been quality validated in ELISA, WB, IHC, and IF applications.
-
產品名稱:Rabbit anti-Homo sapiens (Human) KLRK1 Polyclonal antibody
-
Uniprot No.:
-
基因名:
-
別名:KLRK1; D12S2489E; NKG2D; NKG2-D type II integral membrane protein; Killer cell lectin-like receptor subfamily K member 1; NK cell receptor D; NKG2-D-activating NK receptor; CD antigen CD314
-
宿主:Rabbit
-
反應種屬:Human
-
免疫原:Synthetic peptide of human KLRK1
-
免疫原種屬:Homo sapiens (Human)
-
克隆類型:Polyclonal
-
抗體亞型:IgG
-
純化方式:Antigen?affinity?purification
-
濃度:It differs from different batches. Please contact us to confirm it.
-
保存緩沖液:pH7.4 PBS, 0.05% NaN3, 40% Glycerol
-
產品提供形式:Liquid
-
應用范圍:ELISA, WB, IHC, IF
-
推薦稀釋比:
Application Recommended Dilution WB 1:500-1:2000 IHC 1:50-1:200 IF 1:20-1:100 -
Protocols:
-
儲存條件:Upon receipt, store at -20°C or -80°C. Avoid repeated freeze.
-
貨期:Basically, we can dispatch the products out in 1-3 working days after receiving your orders. Delivery time maybe differs from different purchasing way or location, please kindly consult your local distributors for specific delivery time.
-
用途:For Research Use Only. Not for use in diagnostic or therapeutic procedures.
相關產品
靶點詳情
-
功能:Functions as an activating and costimulatory receptor involved in immunosurveillance upon binding to various cellular stress-inducible ligands displayed at the surface of autologous tumor cells and virus-infected cells. Provides both stimulatory and costimulatory innate immune responses on activated killer (NK) cells, leading to cytotoxic activity. Acts as a costimulatory receptor for T-cell receptor (TCR) in CD8(+) T-cell-mediated adaptive immune responses by amplifying T-cell activation. Stimulates perforin-mediated elimination of ligand-expressing tumor cells. Signaling involves calcium influx, culminating in the expression of TNF-alpha. Participates in NK cell-mediated bone marrow graft rejection. May play a regulatory role in differentiation and survival of NK cells. Binds to ligands belonging to various subfamilies of MHC class I-related glycoproteins including MICA, MICB, RAET1E, RAET1G, RAET1L/ULBP6, ULBP1, ULBP2, ULBP3 (ULBP2>ULBP1>ULBP3) and ULBP4.
-
亞細胞定位:Cell membrane; Single-pass type II membrane protein. Note=Colocalized with HCST on the cell surface.
-
組織特異性:Expressed in natural killer (NK) cells, CD8(+) alpha-beta and gamma-delta T-cells. Expressed on essentially all CD56+CD3- NK cells from freshly isolated PBMC. Expressed in interferon-producing killer dendritic cells (IKDCs).
-
數據庫鏈接:
Most popular with customers
-
YWHAB Recombinant Monoclonal Antibody
Applications: ELISA, WB, IHC, IF, FC
Species Reactivity: Human, Mouse, Rat
-
Phospho-YAP1 (S127) Recombinant Monoclonal Antibody
Applications: ELISA, WB, IHC
Species Reactivity: Human
-
-
-
-
-
-